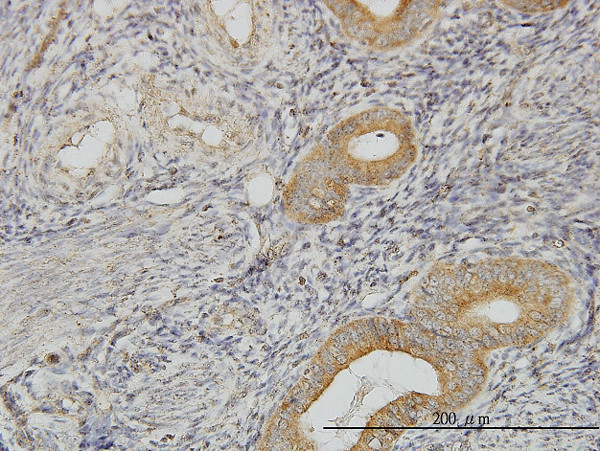
FLJ20643 Antibody in Immunohistochemistry (Paraffin) (IHC (P))

Search
Abnova
FLJ20643 Monoclonal Antibody (1E8)
{{$productOrderCtrl.translations['antibody.pdp.commerceCard.promotion.promotions']}}
{{$productOrderCtrl.translations['antibody.pdp.commerceCard.promotion.viewpromo']}}
{{$productOrderCtrl.translations['antibody.pdp.commerceCard.promotion.promocode']}}: {{promo.promoCode}} {{promo.promoTitle}} {{promo.promoDescription}}. {{$productOrderCtrl.translations['antibody.pdp.commerceCard.promotion.learnmore']}}
产品信息
H00055011-M06
宿主/亚型
分类
类型
克隆号
抗原
偶联物
形式
浓度
规格
保存条件
运输条件
产品详细信息
Sequence of this protein is as follows: MANPKLLGLE LSEAEAIGAD SARFEELLLQ ASKELQQAQT TRPESTQIQP QPGFCIKTNS SEGKVFINIC HSPSIPPPAD VTEEELLQML EEDQAGFRIP MSLGEPHAEL DAKGQGCTAY DVAVNSDFYR RMQNSDFLRE LVITIAREGL EDKYNLQLNP EWRMMKNRPF MGSISQQNIR SEQRPRIQEL GDLYTPAPGR AESGPEKPHL NLWLEAPDLL LAEIDLPKLD GALGLSLEIG ENRLVMGGPQ QLYHLDAYIP LQINSHESKA AFHRKRKQLM VAMPLLLVPS
靶标信息
Involved in the assembly of C/D box small nucleolar ribonucleoprotein (snoRNP) particles (PubMed:17636026). Recruits the SWI/SNF complex to the core promoter of rRNA genes and enhances pre-rRNA transcription (PubMed:22368283, PubMed:24036451). Mediates interaction of TELO2 with the R2TP complex which is necessary for the stability of MTOR and SMG1 (PubMed:20864032). Positively regulates the assembly and activity of the mTORC1 complex (PubMed:24036451).
仅用于科研。不用于诊断过程。未经明确授权不得转售。